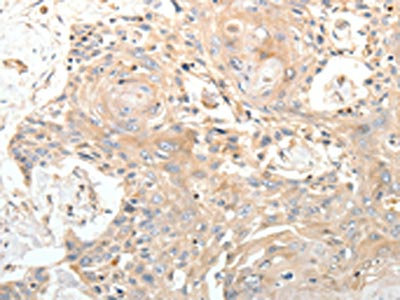

STX1A Antibody
-
中文名稱:STX1A兔多克隆抗體
-
貨號:CSB-PA269128
-
規格:¥1100
-
圖片:
-
The image on the left is immunohistochemistry of paraffin-embedded Human esophagus cancer tissue using CSB-PA269128(STX1A Antibody) at dilution 1/20, on the right is treated with synthetic peptide. (Original magnification: ×200)
-
The image on the left is immunohistochemistry of paraffin-embedded Human gastric cancer tissue using CSB-PA269128(STX1A Antibody) at dilution 1/20, on the right is treated with synthetic peptide. (Original magnification: ×200)
-
Gel: 12%SDS-PAGE, Lysate: 40 μg, Lane: Mouse brain tissue, Primary antibody: CSB-PA269128(STX1A Antibody) at dilution 1/350, Secondary antibody: Goat anti rabbit IgG at 1/8000 dilution, Exposure time: 20 seconds
-
-
其他:
產品詳情
-
Uniprot No.:
-
基因名:
-
別名:HPC 1 antibody; Neuron specific antigen HPC1 antibody; Neuron-specific antigen HPC-1 antibody; OTTHUMP00000174615 antibody; OTTHUMP00000174616 antibody; OTTHUMP00000174617 antibody; OTTHUMP00000174618 antibody; P35-1 antibody; STX1 antibody; STX1A antibody; STX1A_HUMAN antibody; SYN1A antibody; Syntaxin 1A (brain) antibody; Syntaxin 1A brain antibody; Syntaxin-1A antibody
-
宿主:Rabbit
-
反應種屬:Human,Mouse,Rat
-
免疫原:Synthetic peptide of Human STX1A
-
免疫原種屬:Homo sapiens (Human)
-
標記方式:Non-conjugated
-
抗體亞型:IgG
-
純化方式:Antigen affinity purification
-
濃度:It differs from different batches. Please contact us to confirm it.
-
保存緩沖液:-20°C, pH7.4 PBS, 0.05% NaN3, 40% Glycerol
-
產品提供形式:Liquid
-
應用范圍:ELISA,WB,IHC
-
推薦稀釋比:
Application Recommended Dilution ELISA 1:2000-1:5000 WB 1:500-1:2000 IHC 1:15-1:50 -
Protocols:
-
儲存條件:Upon receipt, store at -20°C or -80°C. Avoid repeated freeze.
-
貨期:Basically, we can dispatch the products out in 1-3 working days after receiving your orders. Delivery time maybe differs from different purchasing way or location, please kindly consult your local distributors for specific delivery time.
-
用途:For Research Use Only. Not for use in diagnostic or therapeutic procedures.
相關產品
靶點詳情
-
功能:Plays an essential role in hormone and neurotransmitter calcium-dependent exocytosis and endocytosis. Part of the SNARE (Soluble NSF Attachment Receptor) complex composed of SNAP25, STX1A and VAMP2 which mediates the fusion of synaptic vesicles with the presynaptic plasma membrane. STX1A and SNAP25 are localized on the plasma membrane while VAMP2 resides in synaptic vesicles. The pairing of the three SNAREs from the N-terminal SNARE motifs to the C-terminal anchors leads to the formation of the SNARE complex, which brings membranes into close proximity and results in final fusion. Participates in the calcium-dependent regulation of acrosomal exocytosis in sperm. Plays also an important role in the exocytosis of hormones such as insulin or glucagon-like peptide 1 (GLP-1).
-
基因功能參考文獻:
- Some Autism spectrum disorder patients had haploidy of STX1A gene and lower STX1A gene expression. PMID: 28235601
- Analysing protein mobility, cluster size and accessibility to myc-epitopes the authors show that forces acting on the transmembrane segment produce loose clusters, while cytoplasmic protein interactions mediate a tightly packed state. PMID: 28722652
- Our results suggest that, as in the CNS, CADM1 interactions drive exocytic site assembly and promote actin network formation. These results support the broader hypothesis that the effects of cell-cell contact on beta-cell maturation and function are mediated by the same extracellular protein interactions that drive the formation of the presynaptic exocytic machinery. These interactions may be therapeutic targets for re... PMID: 27072493
- A significant interactive two-locus model of STX1A_rs4363087|VAMP2_rs2278637 (presynaptic genes) was observed among SVC variants in all epilepsy cases. PMID: 27458546
- Mislocalization of syntaxin-1 was found in pluripotent stem cells from epileptic encephalopathy patient. PMID: 26918652
- Blockade of the SNARE protein syntaxin 1 inhibits glioblastoma tumor growth. PMID: 25803850
- SNARE complex genes and their interactions may play a significant role in susceptibility and working memory of ADHD. PMID: 25445064
- We described clinical, genetic, and functional data from 17 families with a diagnosis of benign familial neonatal epilepsy caused by KCNQ2 or KCNQ3 mutations and we showed that some mutations lead to a reduction of Q2 channel regulation by syntaxin-1A. PMID: 24375629
- no associaton with idiopathic generalized epilepsy was found regarding Intron 7 rs1569061 of Syntaxin 1A gene, MnlI rs3746544 and DdeI rs1051312 polymorphisms of SNAP-25 gene compared with healthy subjects PMID: 24164654
- The clinical relevance of STX1A variants in CF PMID: 23572023
- PIP2 affects islet beta-cell KATP channels not only by its actions on Kir6.2 but also by sequestering Syn-1A to modulate Syn-1A availability and its interactions with SUR1 on PM. PMID: 24429282
- Prefusion structure of syntaxin-1A suggests pathway for folding into neuronal trans-SNARE complex fusion intermediate. PMID: 24218570
- N-peptide and LE mutation have no effect on the global conformation of the Munc18a-Syx1a complex. PMID: 23858467
- the preferential binding of CAPS1 to open syntaxin-1 can contribute to the stabilization of the open state of syntaxin-1 during its transition from "closed" state to the SNARE complex formation. PMID: 23801330
- The histone modification marks were significantly increased in bipolar disorder and major depression and this effect was correlated with significant increases in Syn1a gene expression. PMID: 22571925
- syntaxin 1 and SNAP-25 cooperate as SNARE proteins to support neuron survival. PMID: 23403573
- In dementia with Lewy bodies patients there were lower levels of syntaxin in visual cortex compared to controls. PMID: 23242284
- Platelets deficient in Munc18b from a Familial Hemophagocytic Lymphohistiocytosis type 5 had secretion defect. PMID: 22791290
- Exocytotic dysfunctions in schizophrenia are probably related to an imbalance of the interaction between munc18-1a and SNARE (mainly syntaxin-1A) complex. PMID: 21669024
- Direct interaction between syntaxin 1A and the Kv2.1 C-terminus is required for efficient insulin exocytosis and glucose-stimulated insulin secretion. PMID: 22411134
- Nesca directly binds KIF5B, kinesin light-chain and syntaxin-1 PMID: 22404429
- Our results provide support for the hypothesis that STX1A represents a susceptibility gene for migraine PMID: 22250207
- DrrA activation of the Rab1 GTPase on plasma membrane-derived organelles stimulated the tethering of endoplasmic reticulum-derived vesicles, resulting in vesicle fusion through the pairing of Sec22b with the plasma membrane syntaxin proteins. PMID: 22264512
- A Ca(v)3.2/syntaxin-1A signaling complex controls T-type channel activity and low-threshold exocytosis. PMID: 22130660
- Forming an acceptor SNARE complex between syntaxin-1A and SNAP-25 weakens but does not abrogate cholesterol-controlled cluster formation and indicates that the reconstitution process results in equal incorporation of protein at either lipid composition. PMID: 21916482
- Recombinant alpha-SNAP-M105I has greater affinity for the cytosolic portion of immunoprecipitated syntaxin than the wild type protein. PMID: 21789195
- association of STX1A with autism in a trio association study; in the anterior cingulate gyrus region, STX1A expression in the autism group was found to be significantly lower than controls; suggests a possible role of STX1A in pathogenesis of autism PMID: 21118708
- Syntaxin 1A effects may be additive but can be blocked at different concentration ranges of calmodulin, suggesting selective presynaptic targeting to directly regulate exocytosis. PMID: 21976501
- syntaxin 1A, a neuronal regulator of presynaptic vesicle release, may play a role in WS and be a component of the cellular pathway determining human intelligence. PMID: 20422020
- ATP regulates pancreatic beta-cell K(ATP) channel activity, not only by its direct actions on Kir6.2 pore subunit, but also via ATP modulation of Syn-1A binding to SUR1. PMID: 21173146
- Results suggest that variants in RNASEL contribute to susceptibility to early onset and familial forms of prostate cancer. PMID: 20564318
- This protein has been found differentially expressed in thalami from patients with schizophrenia. PMID: 20471030
- We confirmed the involvement of syntaxin 1A in migraine susceptibility regarding rs941298. In addition, we found rs6951030 to also be associated in Portuguese migraine patients. PMID: 20385907
- SNAP-25 traffics to the plasma membrane by a syntaxin-independent mechanism. PMID: 12114505
- Munc18b binds to syntaxins 1A, 2, and 3 and regulates vesicle transport to the apical plasma membrane PMID: 12198139
- CFTR channels are coordinately regulated by two cognate t-SNAREs, SNAP-23 (synaptosome-associated protein of 23 kDa) and syntaxin 1A. PMID: 12209004
- interacts with CFTR protein differently from interactions with SNARE. PMID: 12446681
- Syntaxin/Munc18 interactions in the late events during vesicle fusion and release in exocytosis PMID: 15175344
- interacts with dopamine transporter PMID: 15202772
- A significant genetic association was found between schizophrenia and an intron 7 single nucleotide polymorphism (SNP) tested. Haplotype analysis supported the association with several significant values that appear to be driven by the intron 7 SNP. PMID: 15219469
- cleavage of APP but not syntaxin 1 is independent of cell surface regulation by extracellular ligands PMID: 15316009
- Syn-1A binds both NBFs of SUR1 and SUR2A but appears to exhibit distinct interactions with NBF2 of these SUR proteins in modulating the KATP channels in islet beta cells and cardiac myocytes PMID: 15339904
- Syntaxin-1A actions on sulfonylurea receptor 2A blocks acidic pH-induced cardiac K(ATP) channel activation PMID: 16672225
- Norepinephrine transpossrter/syntaxin 1A complex rapidly redistributes, upon amphetamine treatment, when mechanisms supported by the transporter's NH2 terminus are eliminated. PMID: 17032905
- analysis of the spatially distinct modes of munc18-syntaxin 1 interaction PMID: 17264080
- the mechanisms involved in Syn1A-K(v) interactions vary significantly between K(v) channels, thus providing a wide scope for Syn1A modulation of exocytosis and membrane excitability PMID: 17506992
- the H(abc) domain has a role in membrane trafficking and targeting of syntaxin 1A PMID: 17543282
- A lower frequency of the PRM -352T allele of the STX1A gene in overweight/obese subjects impaires glucose regulation, particularly among individuals with combined glucose intolerance and overt diabetes. PMID: 17912268
- We have identified a new three-gene classifier that is independent of and improves on stage to stratify early-stage NSCLC patients with significantly different prognoses. PMID: 18065728
- The expression of the SNARE protein SNAP-25 and its cellular homologue SNAP-23, as well as syntaxin1 and VAMP (vesicle-associated membrane protein) in samples of normal parathyroid tissue, chief cell adenoma, and parathyroid carcinoma, was examined. PMID: 18457912
顯示更多
收起更多
-
相關疾病:STX1A is located in the Williams-Beuren syndrome (WBS) critical region. WBS results from a hemizygous deletion of several genes on chromosome 7q11.23, thought to arise as a consequence of unequal crossing over between highly homologous low-copy repeat sequences flanking the deleted region.
-
亞細胞定位:Cytoplasmic vesicle, secretory vesicle, synaptic vesicle membrane; Single-pass type IV membrane protein. Cell junction, synapse, synaptosome. Cell membrane.; [Isoform 2]: Secreted.
-
蛋白家族:Syntaxin family
-
組織特異性:Isoform 1 is highly expressed in embryonic spinal chord and ganglia and in adult cerebellum and cerebral cortex. Isoform 2 is expressed in heart, liver, fat, skeletal muscle, kidney and brain.
-
數據庫鏈接:
Most popular with customers
-
-
Phospho-YAP1 (S127) Recombinant Monoclonal Antibody
Applications: ELISA, WB, IHC
Species Reactivity: Human
-
-
-
-
-
-